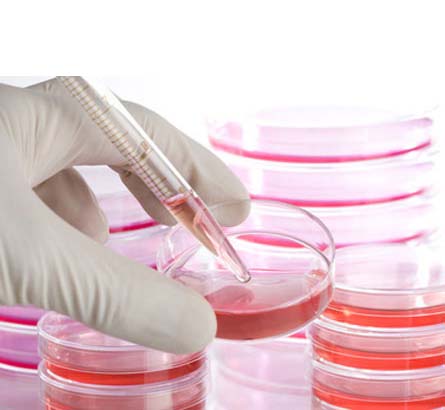

培养基及添加剂
[展开描述+]培养基及添加剂
-
产品货号
产品名称
产品描述
-
用于各种哺乳动物原代细胞、传代细胞系、杂交瘤细胞等的冻存
-
常用的体外培养活组织、细胞的盐溶液
-
经过去离子,反渗,蒸馏和0.10微米过滤,无检测到的DNA...
-
经过去离子,反渗,蒸馏和0.10微米过滤,无检测到的DNA...
-
经过去离子,反渗,蒸馏和0.10微米过滤,无检测到的DNA...
-
经过去离子,反渗,蒸馏和0.22微米过滤,使内毒素含量降低...
-
7.5g/100ml。
-
Prepared in diseilled water。
-
纯度:>99.9%。Millipore Millex-GN...
-
溶于0.85% NaCl溶液。15-30℃保存。
-
溶于D-PBS溶液,0-5℃保存。
-
溶于细胞培养级超纯水,Millipore 0.22μ...
-
含75g/L碳酸氢纳。15-30℃保存。
-
55mM β-巯基乙醇溶于D-PBS。
-
200mM L-谷氨酰胺溶于0.85% NaCl溶液。-2...

